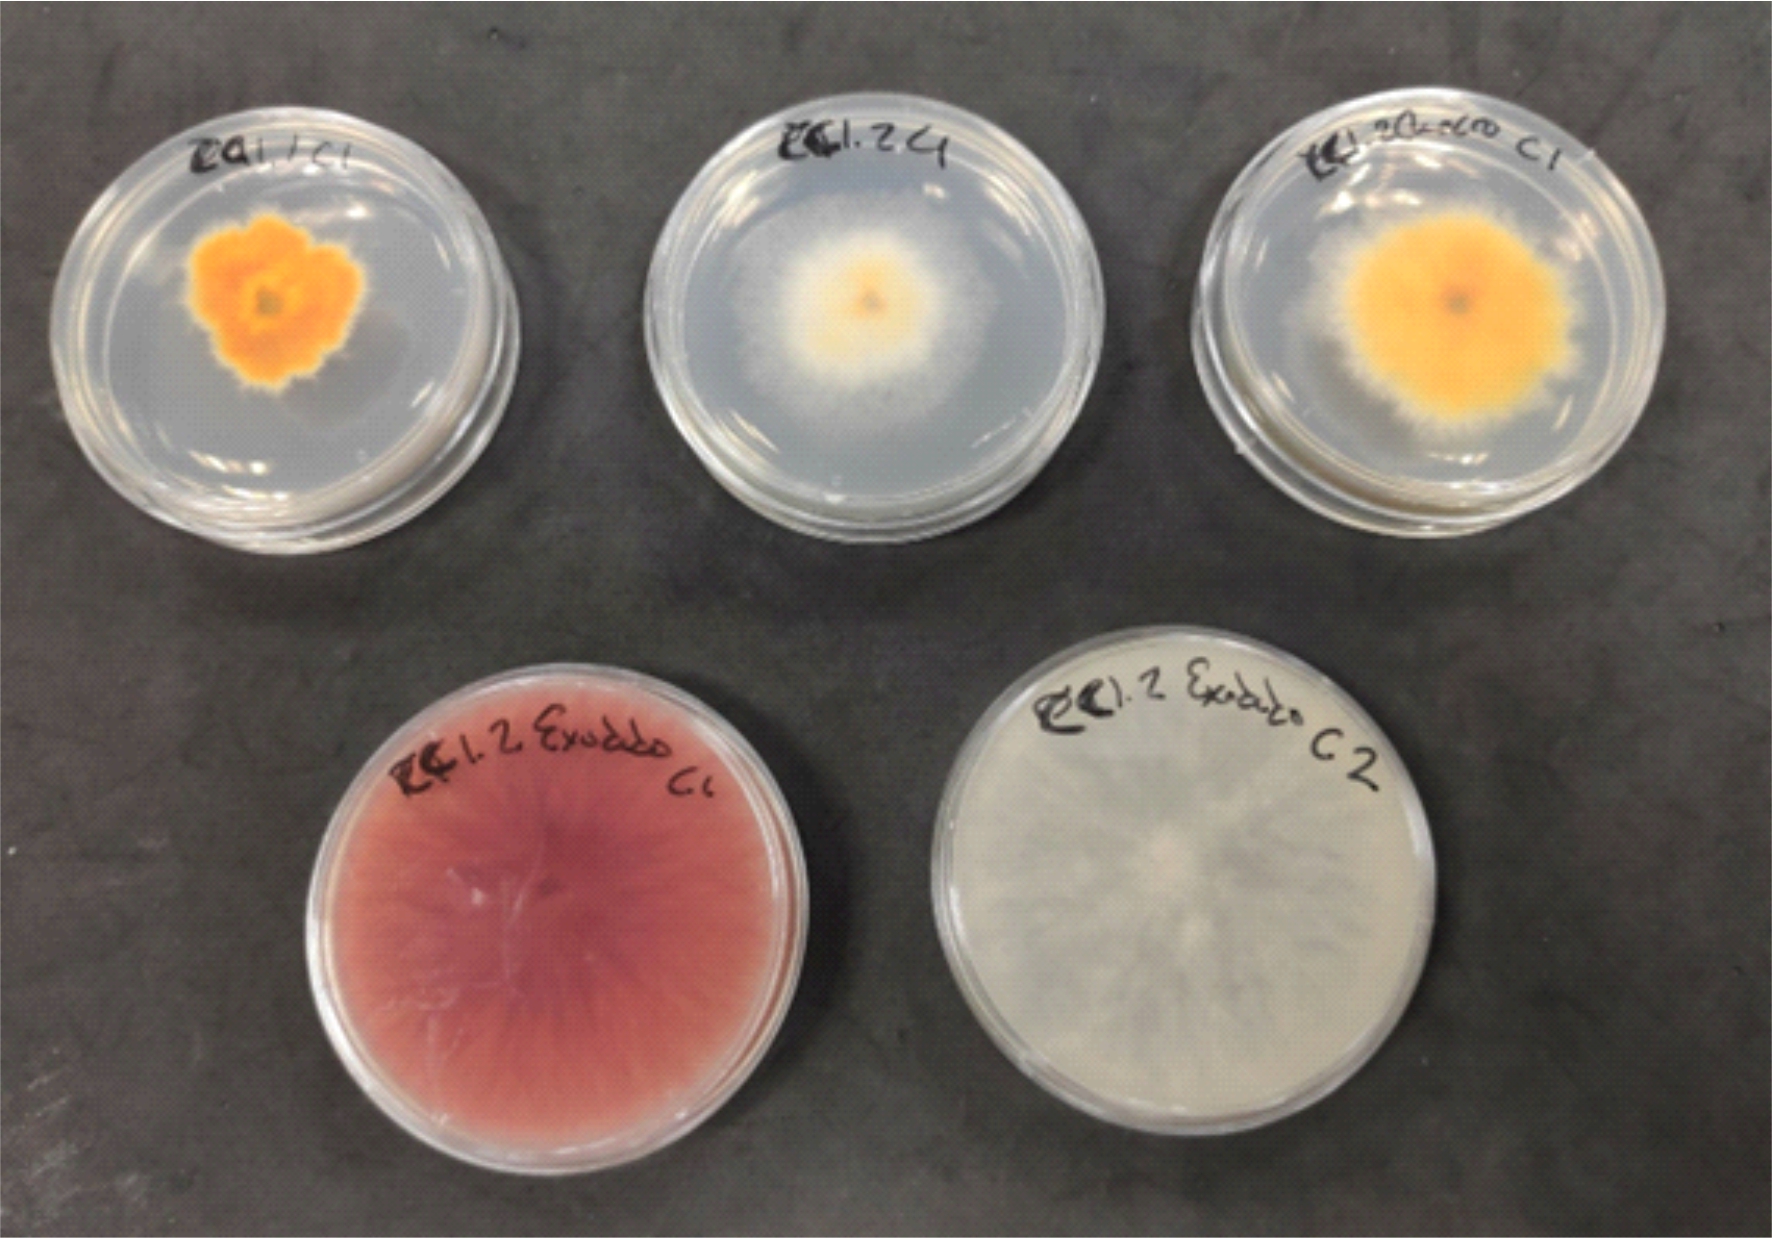

DENDROLab > Laboratorio de Dendrocronología y Modelización Forestal
Situado en la sede iuFOR de Palencia, dispone de instrumental avanzado paro el análisis de datos útiles paro el desarrollo de investigación en Selvicultura Cuantitativa.
RESPONSABLE: Dr. Felipe Bravo – Catedrático de Universidad Producción Vegetal – E.T.S. de Ingenierías Agrarias

LABORATORIO DE MICOLOGÍA APLICADA
Situado en la sede iuFOR de Palencia, cuenta con los instrumentos necesarios para el estudio de hongos.

LABORATORIOS DE EDAFOLOGÍA Y QUÍMICA AGRÍCOLA
Constituyen unas instalaciones de apoyo a la docencia y a la investigación en ciencias del suelo y química agrícola, situadas en la sede iuFOR de Palencia. Son cuatro laboratorios independientes, uno destinado al pretratamiento de muestras y otros tres a su análisis.
RESPONSABLE: Dra. M. Belén Turrión Nieves – Catedrática de Universidad Área de Edafología y Química Agrícola – E.T.S. de Ingenierías Agrarios

LABORATORIO DE CULTIVO IN VITRO
Se dedica a la docencia e investigación en técnicas de cultivo in vitro con fines de propagación clonal y conservación de germoplasma. Situado en la sede iuFOR de Palencia.

LABORATORIO DE PRODUCCIÓN VEGETAL-AGROBIOTECH
Dotado de equipamiento que permite el análisis genético de plantas y otros organismos de interés forestal. Situado en la sede iuFOR de Palencia.
RESPONSABLE: Dr. Oscar Santamaría Becerril – Profesor Titular de Universidad. Producción Vegetal – E.T.S. de Ingenierías Agrarias

LABORATORIO DE PLAGAS Y ENFERMEDADES FORESTALES
Laboratorio de protección forestal dedicado a la docencia e investigación relacionada con el estudio, control biológico y manejo integrado de hongos e insectos forestales. Situado en la sede iuFOR de Palencia.
RESPONSABLE: Dr. Julio Díez Casero – Catedrático de Universidad. Patología Forestal – E.T.S. de Ingenierías Agrarias

LABORATORIO DE TÉCNICAS INSTRUMENTALES
El LTI es un servicio central de la Universidad de Valladolid que depende del Vicerrectorado de Investigación. Tiene su sede principal en el campus de Valladolid y dos pequeñas sedes en los campus de Palencia y de Soria. Este laboratorio está a disposición de la comunidad científica de la universidad, entre la que se encuentra el iuFOR. Ofrece servicios y apoyo en diversos campos científico-tecnológicos utilizando equipamientos y recursos propios de la Universidad de Valladolid.

Colecciones
El iuFOR dispone de una serie de colecciones a disposición de la investigación.
Conócelas y contribuye a su mejora yconservación.

COLECCIÓN DE MONOLITO EDAFOLÓGICOS
El Grupo de Investigación Reconocida (GIR): SQS Suelos, Calidad y Sostenibilidad del iuFOR está creando una colección de monolitos edafológicos de distintos suelos de la provincia de Palencia.
Un monolito es un bloque de suelo extraído con el menor grado de alteración posible y alcanzando la profundidad total del perfil de suelo que proporciona información esencial sobre las propiedades morfológicas del suelo, como color, textura, estructura, actividad biológica y más. Estos monolitos hacen visibles y comprensibles conceptos sobre suelos que, de otra manera, no podríamos observar directamente.
Esta colección trata de dar apoyo docente en las asignaturas relacionadas con el estudio del suelo, además de servir como herramientas de educación, sensibilización y divulgación científica a la sociedad en general.
Actualmente la colección está formada por un perfil de suelo antrópico y tres suelos naturales de distintas características y diferentes zonas palentinas; pero se irá ampliando para cubrir todos los distintos tipos de suelo de las provincias de Palencia y Valladolid, al menos. Los monolitos están expuestos en la E.T.S. de Ingenierías Agrarias e incluyen una explicación del tipo de suelo, sus horizontes y profundidades, sus propiedades, la zona de extracción, etc.


COLECCIÓN DE HONGOS FORESTALES
Desde el año 1990 la colección de hongos forestales recogidos por miembros de IUFOR en la ETSIIAA ha superado las 3600 muestras de especies de interés. Los trabajos científicos de campo han resultado el origen de la llegada de este material. Destacan las colecciones de hongos micorrícicos de los géneros Pisolithus, Scleroderma, Astraeus, Hydnum, Tuber, Terfezia, Suillus, Boletus, etc que se conservan secos. También existe una colección de carpóforos liofilizados que están expuestos en una colección de vitrinas en el Edificio Principal de la ETSIIAA. La ubicación es en la primera planta del Edificio Principal de la ETSIIAA, así como en los laboratorios de Fisiología y Botánica Forestal.
También destaca la colección de plantas de Botánica forestal, con más de 2500 muestras de géneros de especial importancia forestal (Populus, Salix, Quercus, Rhamnus, etc) así como de herbáceas acuáticas, arvenses, etc, dentro del Herbario del área de Botánica Palencia (PALAB). La ubicación es en el espacio conocido como Herbario del Edificio Principal de la ETSIIAA, así como en varios espacios en los laboratorios de Biología, Fisiología y Botánica Forestal.

COLECCIÓN DE PLAGAS Y ENFERMEDADES FORESTALES
Plagas forestales: estudio y la lucha contra insectos-plaga invasores a través de diferentes técnicas de manejo integrado. El grupo es especialista en la cría de Leptoglossus occidentalis, conocida como la chinche americana del pino, de la cual tenemos una población estable en el laboratorio. Esta chinche es un grave problema en las plantaciones de piñones, disminuyendo hasta en un 80% las producciones de piñón y dificultando la regeneración natural de las zonas de pinar.
En el laboratorio de plagas se han desarrollado numerosos avances en torno al control del nemátodo del pino, Bursaphelenchus xylophilus. Este nemátodo es un organismo nocivo que provoca graves daños en las especies del género Pinus sp. y otras coníferas. Su ataque causa el decaimiento súbito de los árboles afectados, produciendo una sintomatología conocida como “seca o marchitamiento de los pinos”.
Enfermedades forestales: diagnóstico y control de diversas patologías de chopos, castaños, pinos y robles causadas por hongos y virus, así como la utilización de métodos de control inocuos para el medioambiente, como el control biológico mediante la utilización de hongos endófitos y RNA interferente.
El grupo también se dedica al estudio de micovirus de agentes fúngicos. se llevan a cabo experimentos destinados a erradicar enfermedades forestales, en concreto, la seca de la encina agravada por el oomiceto Phytophthora y los chancros del pino y el castaño, este último provocado por Chryphonectria parasitica.




